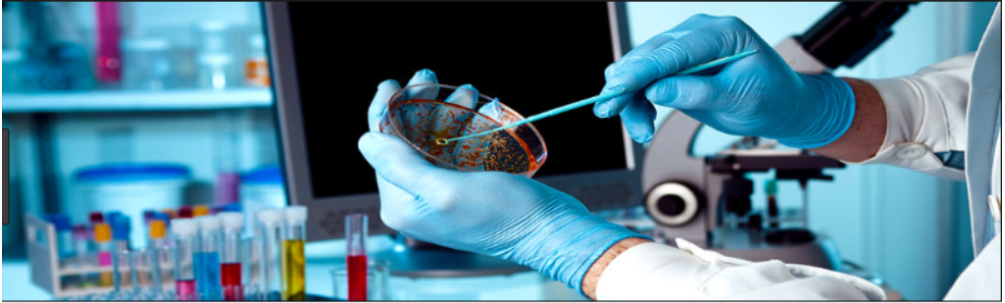

Giới thiệu
CÔNG TY CỔ PHẦN NGHIÊN CỨU VÀ ỨNG DỤNG CÔNG NGHỆ SINH HỌC XANH
Mọi câu chuyện đều có 1 khởi đầu. Với GRAT, chúng tôi bắt đầu câu chuyện của mình từ đam mê và khao khát mang tên: ‘Vì một tương lai XANH – LÀNH – BỀN VỮNG’’
Công ty Cổ Phần Nghiên cứu và Ứng dụng công nghệ sinh học xanh (GRAT) được thành lập tháng 4 năm 2024 bởi một nhóm các thạc sỹ, kỹ sư công nghệ sinh học, thực phẩm có chung đam mê nghiên cứu và khát vọng ứng dụng công nghệ công nghệ sinh học vào cuộc sống.
GRAT hiểu rằng Vi sinh chính là chìa khóa mở cánh cửa kỉ nguyên mới – Kỷ nguyên của Công nghệ sinh học. Chúng tôi tập trung tâm, trí, lực toàn đội ngũ để tạo những bước đột phát trong nghiên cứu và thử nghiệm các sản phẩm mới có tính xu hướng, mang tới giải pháp toàn diện cho một xã hội khỏe mạnh.
Bằng tất cả đam mê, sự tận tụy và quan điểm phát triển bền vững, GRAT sẽ tạo ra các chế phẩm sinh học đột phá tại thị trường Việt Nam trong những năm tới.
Trân trọng!
SỨ MỆNH
|
|
|
TẦM NHÌN
|
|
|
GIÁ TRỊ CỐT LÕI
|
|
|
VĂN HÓA DOANH NGHIỆP
|
|




